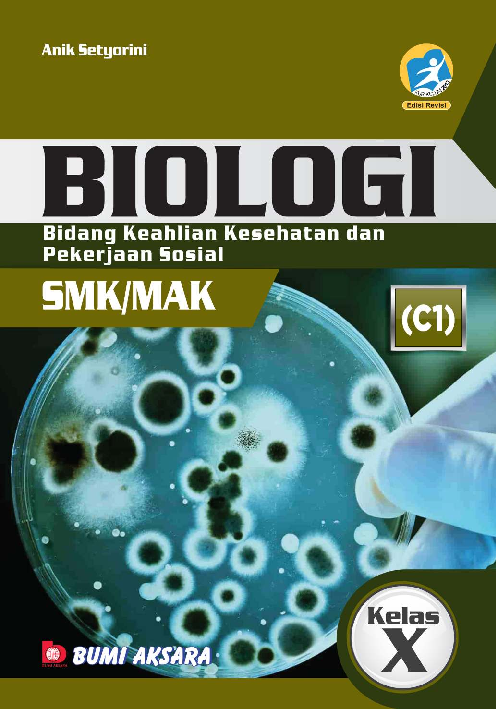
cover buku

Biologi SMK/MAK Kelas X (Bidang Keahlian Kesehatan dan Pekerjaan Sosial)

Deskripsi
Sinopsis
Buku ini ditulis sebagai salah satu sumber belajar siswa SMK/MAK kelas X untuk mempelajari dan memperdalam materi Biologi. Selain itu, buku ini ditulis secara umum dalam rangka ikut serta mencerdaskan bangsa Indonesia di era globalisasi dalam perkembangan ilmu pengetahuan dan teknologi. Buku ini disusun berdasarkan Peraturan Direktur Jenderal Pendidikan Dasar dan Menengah Kementerian Pendidikan dan Kebudayaan Nomor 464/D. D5/KR/2018 tentang Kompetensi Inti dan Kompetensi Dasar Mata Pelajaran Muatan Nasional (A), Muatan Kewilayahan (B), Dasar Bidang Keahlian (C1), Dasar Program Keahlian (C2), dan Kompetensi Keahlian (C3). Anda dapat mempelajari buku ini sebelum dan sesudah dibahas oleh guru dan dapat mendiskusikannya dengan teman agar mendapatkan hasil belajar yang maksimal. Setiap bab dalam buku ini dilengkapi dengan Kompetensi Dasar, Kata Kunci, Peta Konsep, Tugas, Info, Rangkuman, Refleksi Diri, Soal Latihan, dan Proyek. Soal latihan diberikan beberapa jenis, setelah akhir bab dan setiap akhir semester. Pembahasan materi disajikan dengan bahasa yang lugas dan mudah kita pahami, dari pembahasan secara umum ke pembahasan secara khusus. Sebelum membaca rangkuman materi, diharapkan Anda membuat rangkuman sendiri terlebih dahulu, yang nantinya dibandingkan dengan rangkuman dalam buku. Dengan demikian, Anda dapat membandingkan pokok materi yang dianggap penting untuk dirangkum dan meningkatkan pemahaman Anda. Pada akhir buku juga dilengkapi dengan Glosarium dan Indeks.